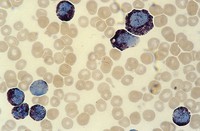

| Tên sản phẩm: | Aquatex aqueous mounting agent for mic Merck |
| Code: | 1085620050 |
| Hãng – Xuất xứ: | Merck – Đức |
| Mã HS: | 3905 99 90 |
| Ứng dụng: |
– Aquatex được sử dụng cho các mẫu nhuộm màu LEUCOGNOST. – Aquatex, là môi trường gắn kết nước nên được sử dụng đặc biệt cho các mẫu được chuẩn bị cho việc xác định enzyme và lipid,100 ml Aquatex là đủ cho khoảng: 200 – 300 mẫu. |
| Tính chất: |
– Tỉ trọng: 1,08 g/cm3 (20 °C) – Giá trị pH: 6,5 – 7,5 (H₂O, 20 °C) – Chỉ số khúc xạ (nD/20): 1.390 – 1.400 – Huỳnh quang (như quinine ở 340nm): ≤ 500 ppb – Độ nhớt (20 °C): 170 – 280 mPa |
| Bảo quản: | Lưu trữ ở + 15 °C đến + 25 °C |
| Quy cách: | Chai nhựa 50 ml |
Aquatex aqueous mounting agent for mic Merck
0 ₫
Aquatex aqueous mounting agent for mic Merck, Code: 1085620050, Quy cách: Chai nhựa 50 ml. Aquatex được sử dụng cho các mẫu nhuộm màu LEUCOGNOST. Ngoài ra còn là môi trường gắn kết nước nên được sử dụng đặc biệt cho các mẫu được chuẩn bị cho việc xác định enzyme và lipid,…
Hãy là người đầu tiên nhận xét “Aquatex aqueous mounting agent for mic Merck” Hủy
Sản phẩm tương tự
Hóa chất thí nghiệm
0 ₫
Hóa chất thí nghiệm
CAL Check™ Chuẩn Mangan Thang Thấp, 0 và 150 μg/L HI96748-11 Hanna
0 ₫
Hóa chất thí nghiệm
CAL Check™ chuẩn Sắt thang cao, 0.00 và 1.50 mg/L HI96721-11 Hanna
0 ₫
Hóa chất thí nghiệm
Titriplex® III solution for 1000 ml, c(Na2-EDTA 2 H2O) = 0.01 mol/l Titrisol® Merck
0 ₫
Hóa chất thí nghiệm
0 ₫
Hóa chất thí nghiệm
0 ₫
Hóa chất thí nghiệm
CAL Check™ Chuẩn Sắt Thang Thấp, 0.00 và 0.80 mg/L HI96746-11 Hanna
0 ₫

Đánh giá
Chưa có đánh giá nào.